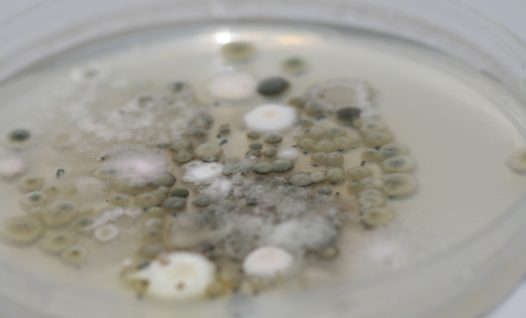
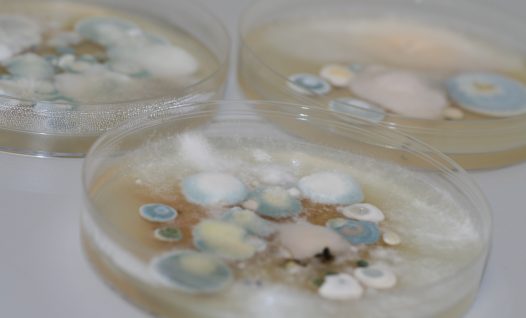
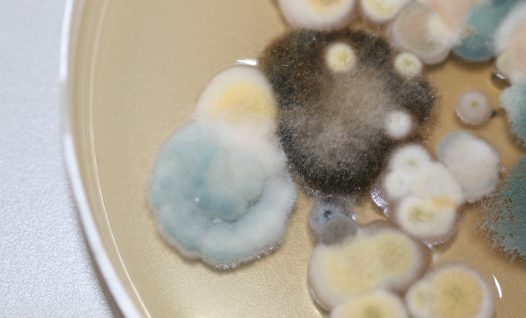

Hallitusseentest
Hallitusseentest
Hallitusseened (rahvakeeli hallitus) on mikroskoopilised seened, mis moodustavad seeneniidistiku, kuid mitte silmaga nähtavaid viljakehasid. Nimetatud struktuuride eristamiseks tuleb alati kasutada mikroskoopi. Hallitusseeni võime leida kõikjal meie ümber – mullas, vees, taimedel ja surnud või kõduneval orgaanilisel materjalil, organismist, välisõhust, ruumiõhust jne. Toitainete suhtes ei ole hallitusseened valivad, nad võivad hakata arenema ja paljunema ka tolmuosakestes. Kõige sagedamini leiame hallitusseente kahjustusi pinnakattevahenditega (värv, lakk vms) töödeldud või tselluloosi sisaldavatel materjalidel (tapeet, kipskartongplaat, puit, soojustusmaterjal jms.). Hallitusseente kasv ja areng nendel toitainetel sõltub peamiselt sobivatest keskkonnatingimustest – temperatuur (0~+40°C), suhteline õhuniiskus (70-100%) ja materjali niiskussisaldus üle 35%.
Hallitusseente mõju tervisele
Niiskusprobleemide ja hallitusseente kasvamise ilmnemisel hakkavad kahjustunud ruumides elavad inimesed kurtma erinevate terviseprobleemide üle. Tekkinud sümptomid võivad olla tingitud pidevast kokkupuutest mikroorganismidega, sh hallitusseentega. Kuna paljud hallitusseened on allergeenid ning võivad ka teatud tingimustel eritada ruumiõhku ohtlikke mükotoksiine, tuleks probleemi tekkimisel või kahtluse korral teada saada, kui palju hallitusseenteeoseid ja -osakesi ruumiõhus leidub ning millised liigid esinevad.
Rohkem teadmisi hallitusseente olemuse, arengu ning eriti kasvukeskkonna osas hoonetes leiad raamatust “Hallitusest – puust ja punaseks. Ehitusinseneri vaatenurgast”. Raamat on müügil meie veebipoes: https://veebipood.mycology.ee/